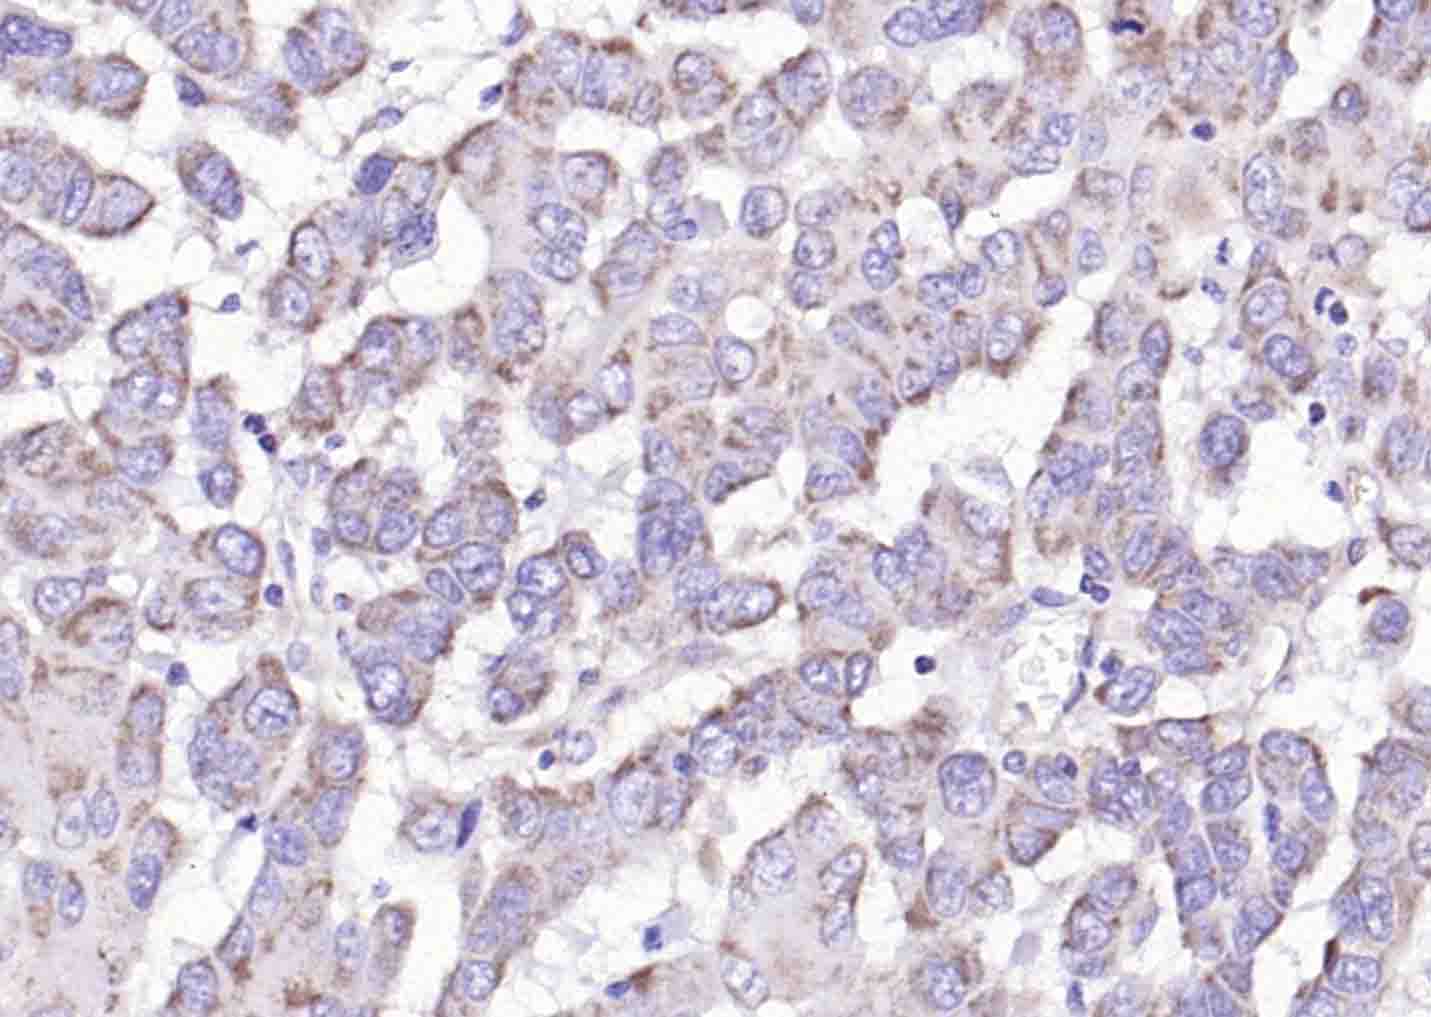
产品细节图片4

相关产品推荐更多 >
万千商家帮你免费找货
0 人在求购买到急需产品
- 详细信息
- 文献和实验
- 技术资料
- 应用范围:
产品信息以Bioss网站为准
- 规格:
50ul/100ul/200ul
| 规格: | 50ul | 产品价格: | ¥1180.0 |
|---|---|---|---|
| 规格: | 100ul | 产品价格: | ¥1980.0 |
| 规格: | 200ul | 产品价格: | ¥2800.0 |
| 产品编号 | bs-15222R |
| 英文名称 | C6orf145 Rabbit pAb |
| 中文名称 | 6号染色体开放阅读框145抗体 |
| 英文别名 | C6orf145; PXDC1_HUMAN; Chromosome 6 open reading frame 145; PX domain containing 1; PX domain-containing protein C6orf145. |
| 产品应用 | IHC-P=1:100-500, IHC-F=1:100-500, IF=1:100-500 Not yet tested in other applications. |
| 交叉反应 | Human, Mouse, Rat (Dog, Pig, Cow) |
| 抗体来源 | Rabbit |
| 免疫原 | KLH conjugated synthetic peptide derived from human C6orf145 |
| 亚型 | IgG |
| 性状 | Liquid |
| 纯化方法 | affinity purified by Protein A |
| 克隆类型 | Polyclonal |
| 理论分子量 | 27 kDa |
| 浓度 | 1mg/ml |
| 储存液 | 0.01M TBS (pH7.4) with 1% BSA, 0.02% Proclin300 and 50% Glycerol. |
| 相似性 | Contains 1 PX (phox homology) domain. |
| 保存条件 | Shipped at 4℃. Store at -20℃ for one year. Avoid repeated freeze/thaw cycles. |
| 注意事项 | This product as supplied is intended for research use only, not for use in human, therapeutic or diagnostic applications. |
| 背景资料 | Making up nearly 6% of the human genome, chromosome 6 contains around 1,200 genes within 170 million base pairs of sequence. Deletion of a portion of the q arm of chromosome 6 is associated with early onset intestinal cancer suggesting the presence of a cancer susceptibility locus. Porphyria cutanea tarda is associated with chromosome 6 through the HFE gene which, when mutated, predisposes an individual to developing this porphyria. Notably, the PARK2 gene, which is associated with Parkinson's disease, and the genes encoding the major histocompatiblity complex proteins, which are key molecular components of the immune system and determine predisposition to rheumatic diseases, are also located on chromosome 6. Stickler syndrome, 21-hydroxylase deficiency and maple syrup urine disease are also associated with genes on chromosome 6. A bipolar disorder susceptibility locus has been identified on the q arm of chromosome 6. The C6orf145 gene product has been provisionally designated C6orf145 pending further characterization. |
| 应用 | 推荐稀释比例 |
| {IHC-P} | {1:100-500} |
| {IHC-F} | {1:100-500} |
| {IF} | {1:100-500} |

风险提示:丁香通仅作为第三方平台,为商家信息发布提供平台空间。用户咨询产品时请注意保护个人信息及财产安全,合理判断,谨慎选购商品,商家和用户对交易行为负责。对于医疗器械类产品,请先查证核实企业经营资质和医疗器械产品注册证情况。
 文献和实验
文献和实验= NAL), appears to form upon oxidative cyclization of the nonfluorescent 2:1 lysine-HNE Michael adduct-Schiff base cross-link (Scheme 1). Polyclonal antibody (PAb) to the NAL-HNE fluorophore was raised in rabbit and found to be highly specific
GE Healthcare Benzamidine Sepharose™ 6B is p-aminobenzamidine covalently attached to Sepharose 6B by the epoxy coupling method. p-Aminobenzamidine (PAB), is a synthetic inhibitor of trypsin-like serine protease. Trypsin and trypsin
Nucleic Acid Programmable Protein Arrays: Versatile Tools for Array‐Based Functional Protein Studies
.g., Sigma) 50 mg/ml bis‐sulfosuccinimdylsuberate (BS3 ;Pierce, cat. no. PI 21580) in dimethylsulfoxide (DMSO) 5 mg/ml
 技术资料
技术资料暂无技术资料 索取技术资料










